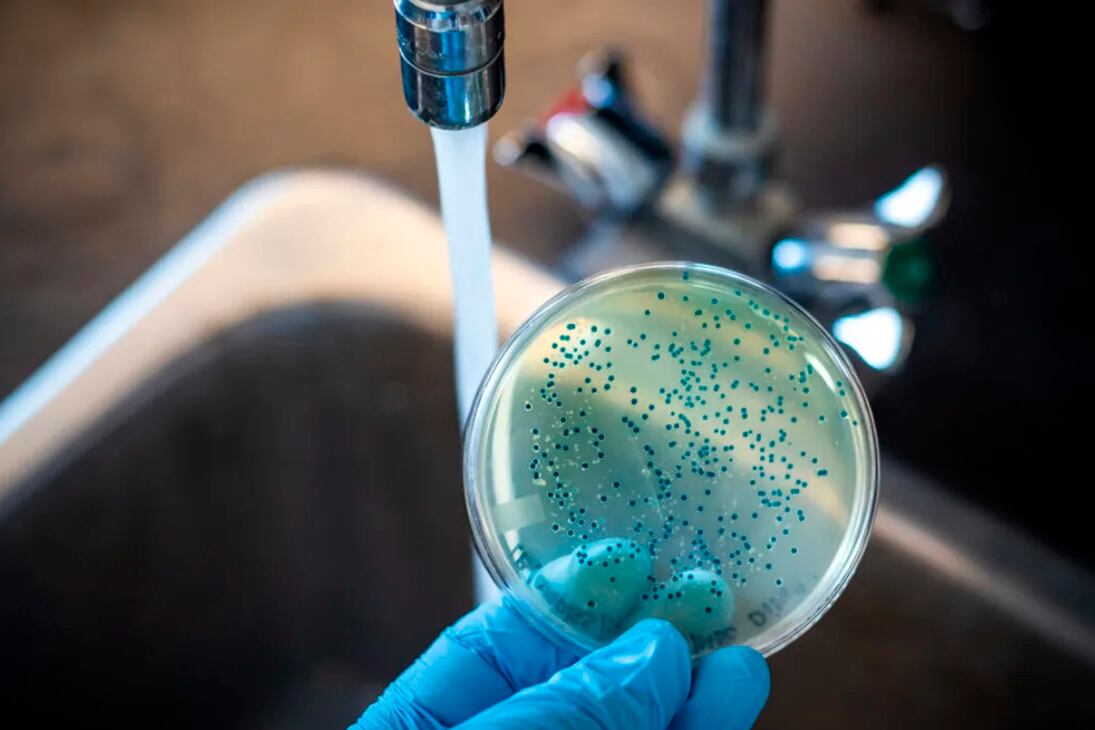
La fiebre tifoidea llega en el agua.

- Edición Impresa
- 50 Años del Golpe
- El País
- Economía
- Sociedad
- Deportes
- El Mundo
- Opinión
- Contratapa
- Recordatorios
- Cultura
- Cash
- Radio 750
- Buenos Aires|12
- Rosario|12
- Salta|12
- Argentina|12
- Radar
- Radar Libros
- Soy
- Las12
- No
- Negrx
- Ciencia
- Universidad
- Psicología
- La Ventana
- Plástica
- Diálogos
- Opens in new window
- Suplementos Especiales
- Latinoamérica Piensa
- Malena
- Público